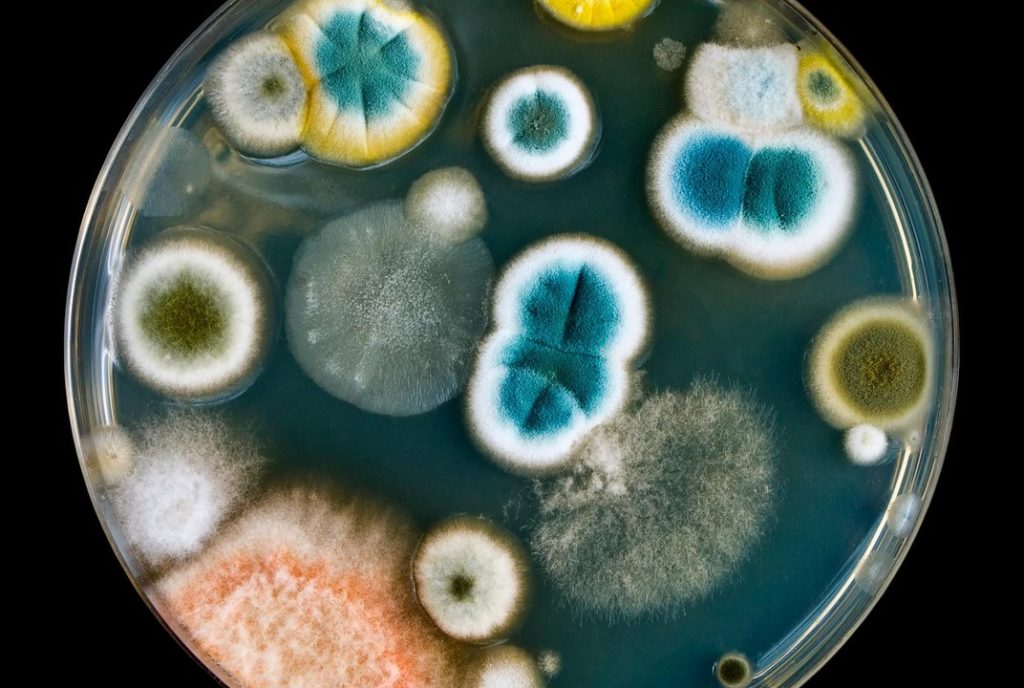
disbiosi fungina

I benefici del Biofeedback per l’ipertensione
![i benefici del biofeedback per l ipertensione]()


L'ipertensione arteriosa provaca un aumento eccessivo della pressione del sangue sui vasi della circolazione mettendo…
Longeva ®25 Marzo 2021